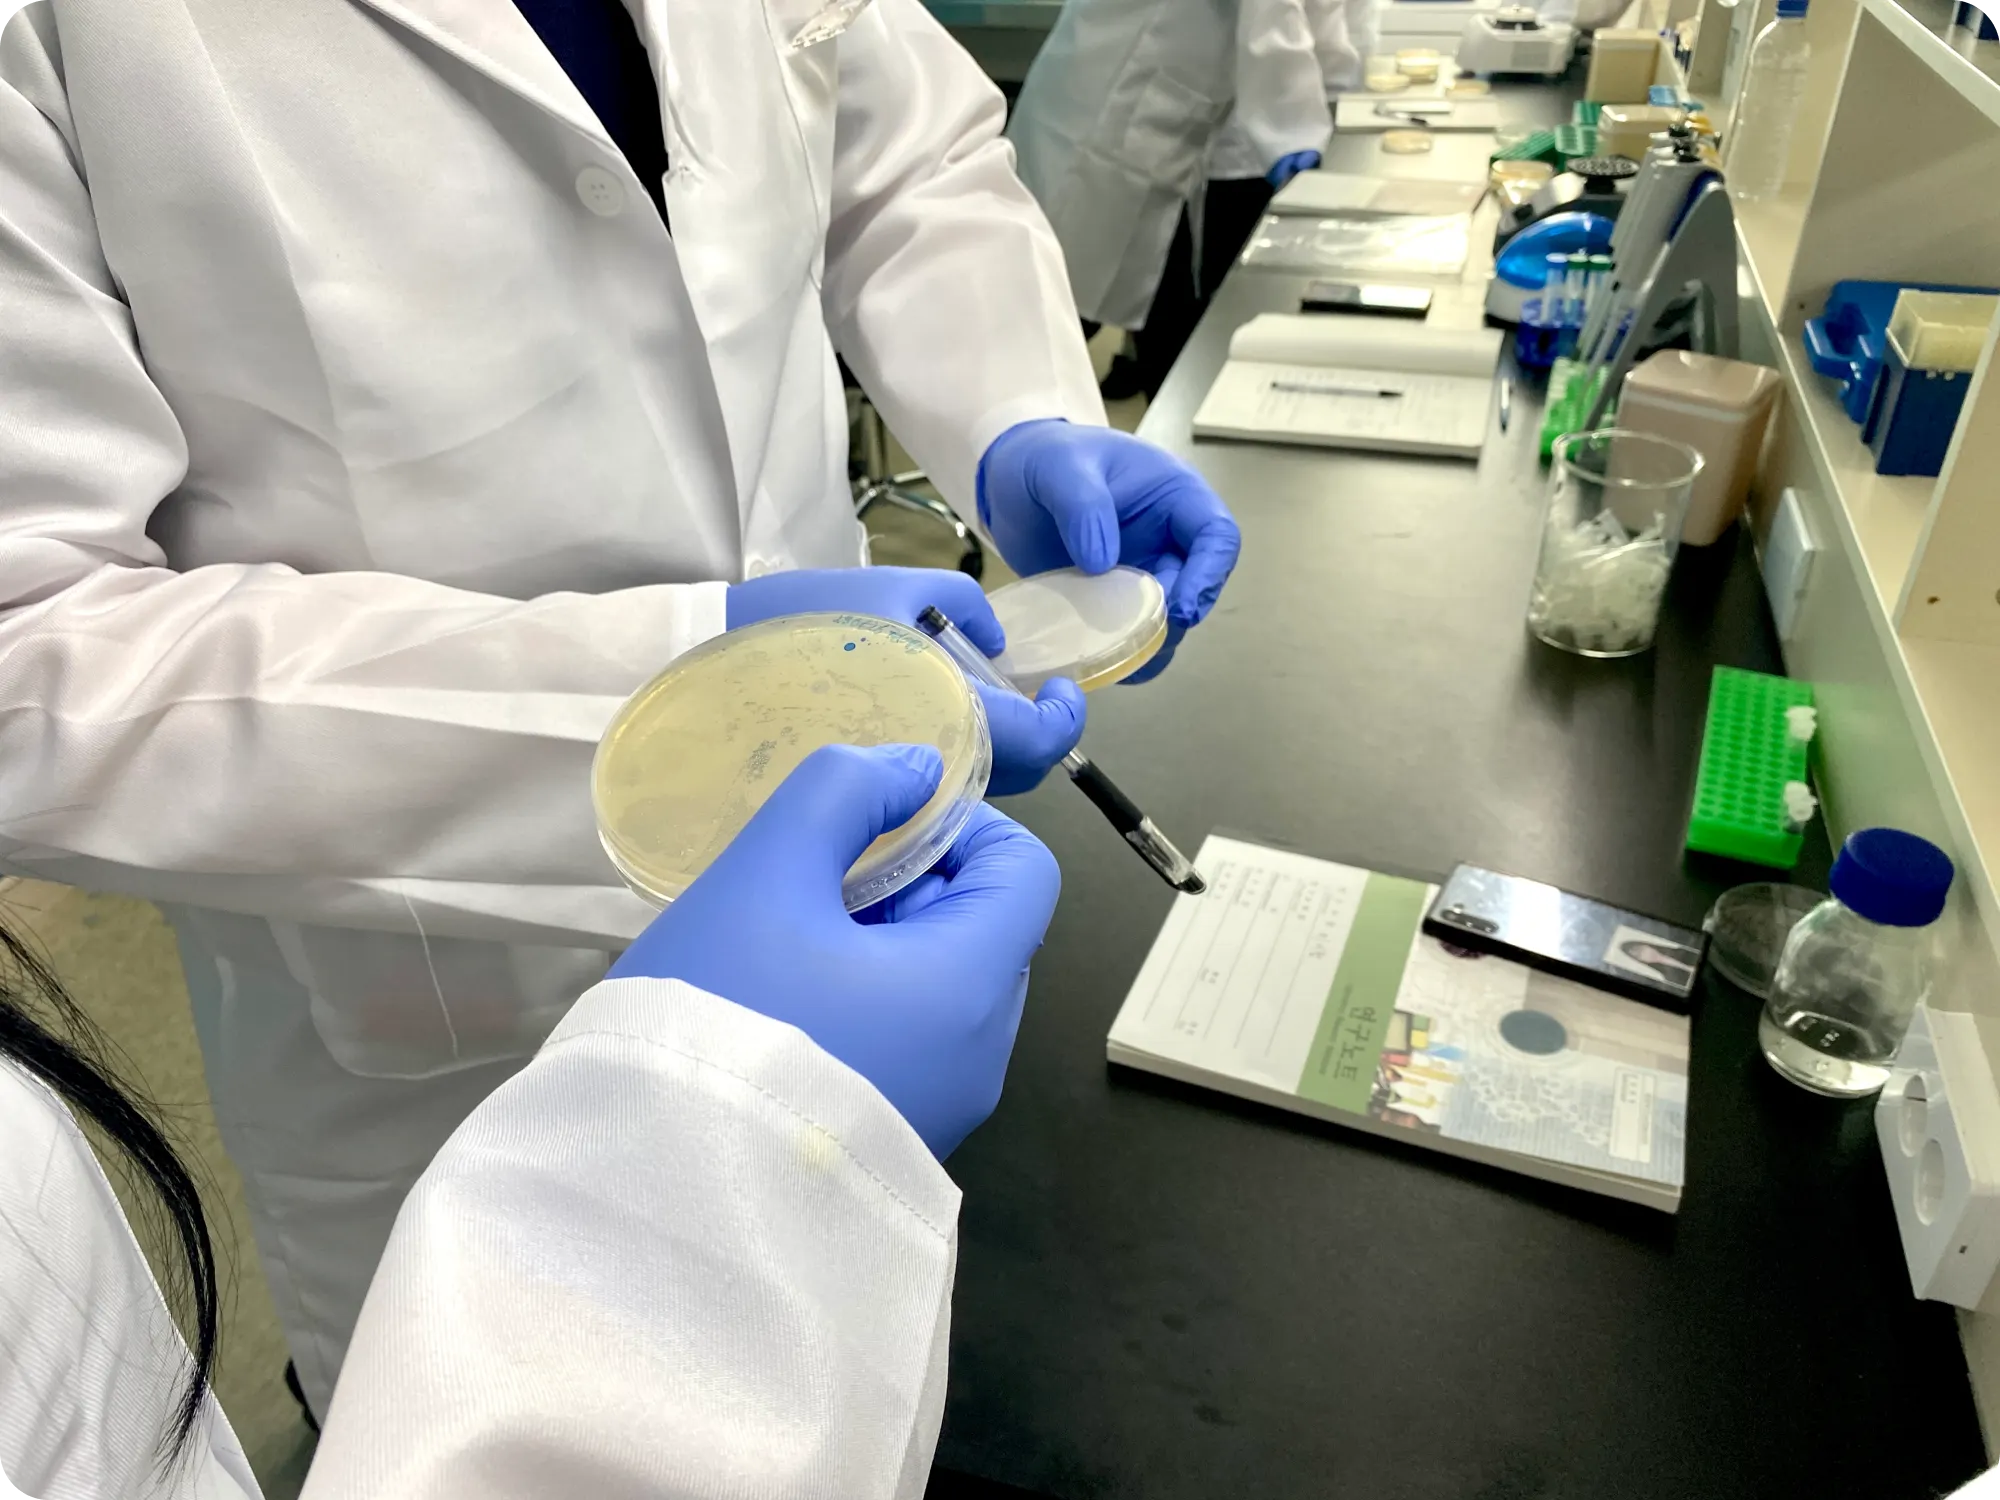

끊임없이 고민해요
비긴랩은 말로만 실무 교육이라고 이야기 하지 않습니다. 저희를 거친 수료생은 ‘즉시 실무에 던져져도 퍼포먼스를 내야만 한다’가 교육 모토입니다. 그래서 어떻게 하면 실무를 접할 수 있을까 끊임없이 고민하고 교육 말고도 실무와 친해질 수 있는 교육기법을 찾았습니다.
현장을 이해하자
비긴랩 수강생은 일련의 실무 프로세스에 맞춰 실습형 교육을 진행합니다.
바이오의약 취업캠프
바이오 취업캠프는 책상에 가만히 앉아서 지겨운 생물학 수업을 듣는 과정이 아닙니다. 비긴랩의 채용 파트너사를 적극 활용하여 지금 사용되는 프로토콜 그러니까 업무 매뉴얼(인수인계용)을 제공받아 그에 기반한 훈련을 진행합니다. 사진이나 영상으로 테크니션을 배우지 않고 직접 비커와 삼각 플라스크, 파이펫(pipette) 등을 만져보며 실험을 수행하고 그 결과를 연구노트에 작성합니다. 그 연구노트는 기업에도 보여주고 면접에서도 탁월한 효과를 보입니다. 덕분에 비전공자임에도 직무 역량을 인정 받을 수 있습니다.